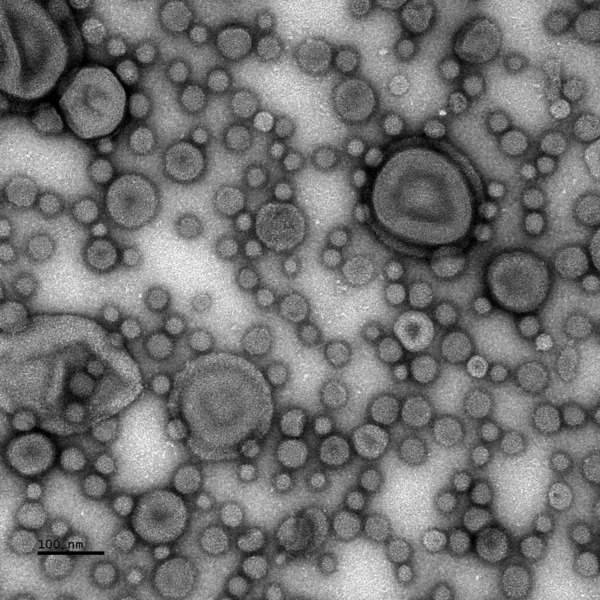

Please note that registration does not guarantee you a place in a course, especially when there is a limited number of places. You will be notified by the course organiser if you are accepted to the course. The organiser will also provide you with the course schedule and detailed information about the course.
The KBC Communication office is supporting with announcement and organisation. Contact the communication officers for general questions at info.kbc@umu.se.